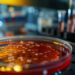
The Potential of Modified Mushrooms in Transforming Meat Alternatives The Potential of Modified Mushrooms in Transforming Meat Alternatives

Quotes from Fortune, May 17, 2024
BY SONYA COLLINS
Heading out to grab a meat meal presents a plethora of decisions: Should it be fries or onion rings on the side, a classic bun or a lettuce wrap, and between a beef patty or a plant-based meat, which one to pick? Naturally, one might lean towards plant-based meat, assuming it’s the more nutritious and healthy option, isn’t that so?
Even though there are vegan alternatives to just about any meat product out there, including beef burgers, chicken nuggets, hotdogs, breakfast sausages, and even beef jerky, the nutritional value may not be as impressive as you had hoped.
The perception that plant-based products are inherently beneficial to health is a common one. However, this is not always the case. D. Julian McClements, a renowned food science expert at the University of Massachusetts Amherst with a focus on plant-based nutrition, points out that the health value of such products is contingent upon the methods employed in their creation. The design process by the manufacturers plays a crucial role in determining whether these plant-based offerings are indeed advantageous to health.
How does plat-based meat differ from other meats?
The worldwide market for plant-based meats, also known as meat substitutes, is expansive. It reached a valuation of approximately $18.78 billion in the year 2023 and is anticipated to grow significantly, with expectations to approach double its current size by the year 2032.
Traditional veggie burgers are commonly composed of a blend of legumes and vegetables, which are combined and shaped into a burger form. This process often leaves the individual ingredients—such as black beans, lentils, maize, and chickpeas—visible, highlighting the natural composition of these items. On the other hand, the latest generation of plant-based meat substitutes, with prominent labels like Beyond and Impossible leading the charge, offers a culinary experience that mirrors traditional meat products more closely than ever before. These brands utilize ingredients derived from less obvious plant sources—like pea protein in the case of Beyond and soy for Impossible—through a comprehensive extraction process to achieve their meat-like qualities.
McClements notes that these items are unmistakably within the category of ultra-processed goods. The term ‘Ultra-processed’ is multifaceted; it can imply a reduction in healthfulness, yet it may also suggest a more healthful option compared to other choices.
Can plant-based meat be beneficial to your health?
As meat substitutes strive to achieve a taste and texture similar to that of actual meat, their level of processing tends to increase. This escalation in processing is where potential issues may arise.
Initially, the excessive processing of foods can strip them of their inherent nutritional benefits. The American Medical Association notes that when natural foods are deconstructed and reshaped into different products, such as corn chips or soy patties, a significant portion of their original fiber content dissipates. Foods with reduced fiber content are metabolized more rapidly, leading to a rapid increase in blood sugar levels and a less fulfilling sensation compared to their whole, unaltered counterparts. While occasionally indulging in such foods is acceptable, a habitual intake of heavily processed foods may contribute to excessive eating, weight gain, and an increased risk of diabetes.
The issue lies with ultra-processed foods as a whole. Specifically, imitation meats may present additional challenges.
To make these meatless burgers as greasy as a beef burger, you need to add fat, and that fat comes in the form of sunflower, coconut, or canola oil, which are usually added in the form of additional fat. This inclusion accounts for the comparable, and occasionally higher, levels of saturated fat found in these alternatives, which have the potential to elevate cholesterol, akin to what one might find in a standard frozen beef burger.
Moreover, these meat substitutes can contain up to five times the sodium content. While they do offer carbohydrates that may impact blood sugar levels, it’s noteworthy that a portion of these carbs is actually fiber—a beneficial nutrient that meat does not provide. Calorically, these plant-based options are on par with their beef counterparts, with an average energy content of approximately 2 to 2.5 calories per gram, equating to 200 calories for a patty weighing 3.5 ounces.
Judy Simon, a registered dietitian at the Nutrition Clinic of UW Medical Center in Seattle, emphasizes the importance of understanding the contents of your food choices and assessing them against the alternatives you consider.
Plant-based meat: what does the science have to say about it?
In a modestly scaled research project published in November 2020 by the American Journal of Clinical Nutrition, a cohort of 36 individuals was observed over a period of 16 weeks. During the first half of the study, participants consumed two portions of animal-based proteins daily, including varieties such as pork, hamburgers, sausages, and ground beef. In the subsequent eight weeks, their diet was substituted with an equivalent amount of Beyond brand plant-based alternatives.
The participants were divided, with one half starting with the animal protein regimen and the other with the plant-based one before switching halfway through. Consistency was maintained in other lifestyle factors such as exercise routines and total caloric consumption throughout the entire duration of the study. Notably, the phase involving the plant-based protein diet resulted in most participants experiencing weight reduction and a decrease in low-density lipoprotein cholesterol, commonly referred to as ‘bad’ cholesterol.